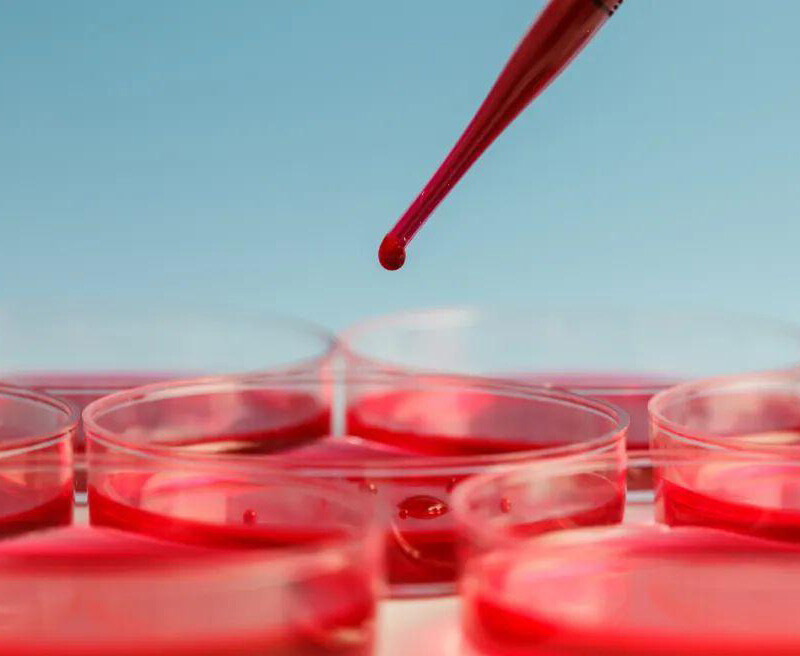
Beta thalassaemia Major

ABOUT THALASSAEMIA
 How important is pre marital and pre pregnancy screening for thalassemia
How important is pre marital and pre pregnancy screening for thalassemiaRead More
 CRISPR-Cas9 gene editing technology for the treatment of sickle cell disease and transfusion dependent beta thalassemia
CRISPR-Cas9 gene editing technology for the treatment of sickle cell disease and transfusion dependent beta thalassemiaRead More
 β thalassemia
β thalassemiaRead More
 The Role of Red Blood Cells in Anemia
The Role of Red Blood Cells in AnemiaRead More
 How is thalassaemia treated?
How is thalassaemia treated?Read More
 Beta thalassaemia Major
Beta thalassaemia MajorRead More
 Beta thalassaemia intermedia
Beta thalassaemia intermediaRead More
 Sickle Beta thalassaemia
Sickle Beta thalassaemiaRead More
 Alpha thalassaemia
Alpha thalassaemiaRead More
 Thalassaemia trait/ minor
Thalassaemia trait/ minorRead More
 Types ofthalassaemia
Types ofthalassaemiaRead More
 How is thalassaemia diagnosed?
How is thalassaemia diagnosed?Read More
 What is thalassaemia?
What is thalassaemia?Read More

{item.title}
Read More
Hi, I am Anya.
Welcome to my website.